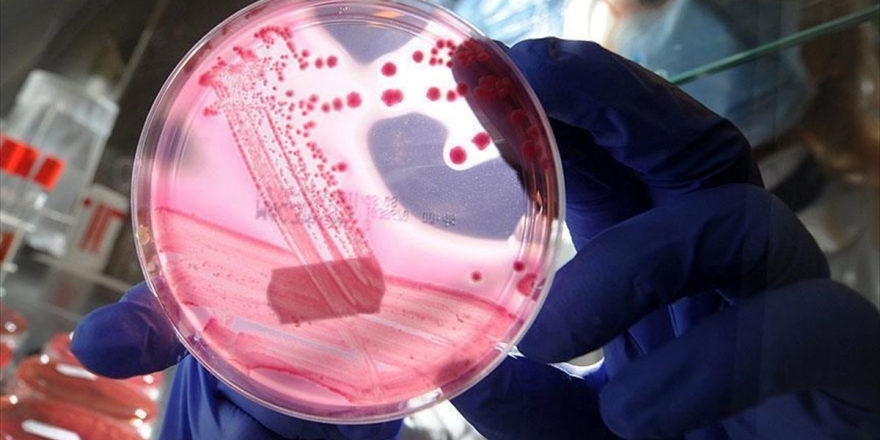
Vücudunda Yağ Oranı Artanlara Meme Kanseri Uyarısı

8. Boğaziçi Film Festivali Yarın Başlıyor
Kültür ve Turizm Bakanlığı Sinema Genel Müdürlüğünün katkıları, Global İletişim Ortağı Anadolu Ajansının destekleriyle düzenlenecek 8. Boğaziçi Film Festivali, yarın seyircisiyle buluşuyor
Kültür ve Turizm Bakanlığı Sinema Genel Müdürlüğünün katkıları, Global İletişim Ortağı Anadolu Ajansının destekleriyle düzenlenecek 8. Boğaziçi Film Festivali, yarın seyircisiyle buluşuyor.
Son dönemin çok beklenen ve ödüllü filmlerini "#HerŞeyeRağmen" sloganıyla sinemaseverlerle buluşturacak 8. Boğaziçi Film Festivalinin açılışı, İranlı yönetmen Majid Majidi'nin son filmi "Sun Children" ile yapılacak.
Festivalde yarın
8. Boğaziçi Film Festivali'nin ilk gününde Ulusal Uzun Metraj Film Yarışması, Uluslararası Uzun Metraj Film Yarışması, Uluslararası Kısa Belgesel Film Yarışması'nda yer alan filmler ve açılış filminin gösterimi yapılacak.
Beyoğlu Sineması'nda 13.00 ve 15.30 seanslarında Uluslararası Kısa Belgesel Film Yarışması'nda yer alan "3 Logical Exits", "Ceuta's Gate", "Clebs", "I Feel Your Eyes", "Outside the Oranges are Blooming", "The Eagles of Carthage", "The Golden Buttons" ve "Then Comes the Evening"in gösterimleri yapılacak. 18.00 seansında "Nasipse Adayız" filminin gösterimi ekip katılımlıyla gerçekleşecek. 21.00 seansında ise sinemaseverler festivalin açılış filmi "Sun Children"ı izleme fırsatı bulacak.
Sinemaseverler Kadıköy Sineması'nda ise 13.00 seansında "Focus", "Grandma", 15.30 seansında "Zana", 18.00 seansında "Ordinary Justice" ve 21.00 seansında ise açılış filmi "Sun Children"ı izleyebilecek.
30 Ekim'de sona erecek festivalin ayrıntılı programına www.bogazicifilmfestivali.com adresinden ulaşılabilir.
Kaynak:![]()

Türkçe karakter kullanılmayan ve büyük harflerle yazılmış yorumlar onaylanmamaktadır.